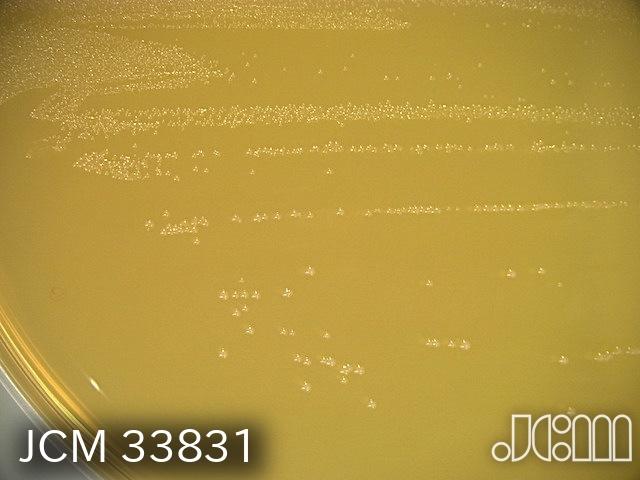

forum.index.hu
Magyarország első és legnagyobb fórum szolgáltatása. A web kettő pre-bétája, amit 1997 óta töltenek meg tartalommal a fórumlakók. Fórumok változatos témákban, hangnemben, moderálva. Ha nem csak megosztani akarsz, hanem diskurálni egy egy témában, csatlakozz Te is, és ha kitartó vagy, társakra találhatsz.
A Fórum otthont ad számos zárt klubfórumnak is, azok számára, akik készek az önszabályozás szellemében együtt élni ebben a virtuális közegben.